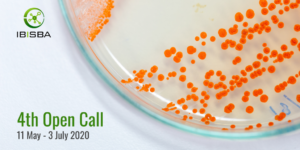

IBISBA : 4e appel à projets
Le 4e appel à projets IBISBA est ouvert du 11 mai au 3 juillet 2020. Il fait partie du programme d’accès transnational (IBISBA-TNA).
Le 4e appel à projets IBISBA est ouvert du 11 mai au 3 juillet 2020. Il fait partie du programme d’accès transnational (IBISBA-TNA).
Les projets qui correspondent aux objectifs d’IBISBA et qui répondent aux exigences techniques, scientifiques et éthiques bénéficieront de services subventionnés et d’une contribution aux frais de déplacement et de séjour*.
*En raison de la situation actuelle liée au covid-19, les déplacements vers les installations d’IBISBA pourraient être soumis à des restrictions.
Les bénéficiaires sont des chercheurs du monde universitaire, des centres de recherche du secteur public ou de l’industrie, travaillant soit dans les États membres de l’UE, soit dans les pays associés et plus exceptionnellement dans des pays tiers. Ils doivent être engagés dans la conception ou la création de nouvelles connaissances, produits, processus, méthodes et systèmes, ainsi que dans la gestion de projets.
L’offre de services du cycle IBISBA DBTLP
Les candidats peuvent choisir parmi les catégories Design, Build, Test, Learn, Process et demander jusqu’à 3 services facilitateurs dans les domaine suivants : biologie synthétique ; génétique, biochimie ; bioinformatique, biomédical ; production alimentaire ; énergie ; biotechnologie et assainissement de l’environnement.
TWB propose notamment son offre de service liée à ses plateformes :
- Ingénierie de souche (construction, screening, évolution);
- Bioprocédés : fermentation, analytique.
Retrouvez ici toutes les directives de candidature et informations nécessaires pour candidater.
Date limite pour candidater : 3 juillet 2020 (17.00 – heure de Bruxelles)
Rappel IBISBA
Lancé en 2015 avec INRAE, l’initiative européenne Industrial Biotechnology Innovation and Synthetic Biology Acceleration (IBISBA) est un programme de regroupement d’infrastructures européennes visant à soutenir et accélérer les projets de biotechnologies industrielles. Le réseau rassemble plusieurs plateformes couvrant l’ensemble du processus de recherche depuis les phases de conception jusqu’à la production. IBISBA a pour vocation de coordonner l’action de ces plateformes pour lever les verrous tant biologiques que technologiques rencontrés lors du développement d’un bioprocédé industriel. Ce projet rassemble 14 infrastructures de 9 pays européens dont VVT (Finlande), RWTH Aachen University, Fraunhofer IGB/CBP (Allemagne) ou encore Manchester Institute of Biotechnology (Royaume-Uni).
En se concentrant sur les différentes phases de R&D dans le développement des bioprocédés, IBISBA offre des services liés à la conception assistée par ordinateur de biomolécules, à la construction d’enzymes et de souches microbiennes, à la fermentation, aux étapes de « downstream processing » et à la gestion des actifs de connaissances du projet.
La Commission Européenne (CE) a incorporé cette infrastructure sur sa feuille de route ESFRI (European Strategy Forum on Research Infrastructures) et a approuvé en août 2019 le projet « PREP-IBISBA », visant à mettre en place cette infrastructure de recherche sous forme d’une entité légale autonome avec son business model, son business plan et sa feuille de route scientifique, avec un financement de 4 M€ sur 4 ans.


